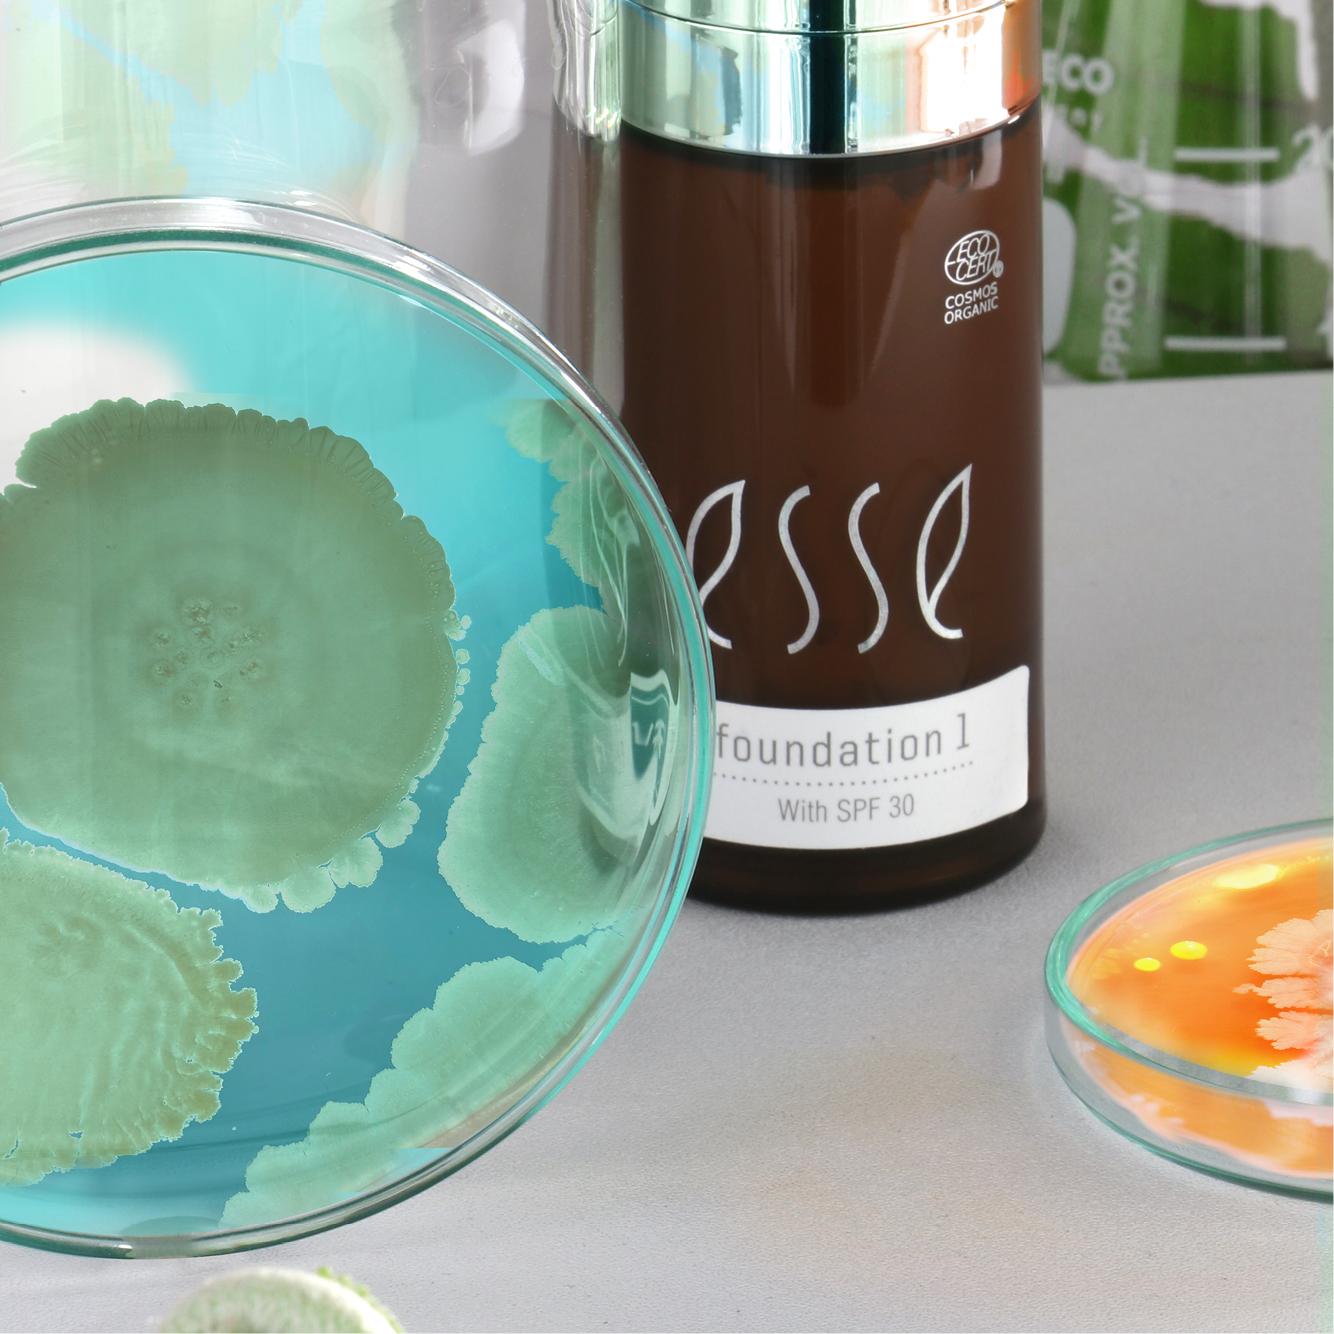

Live vs Non-Living: Why Live Probiotics Offer Better Skin Benefits
As one of the very first brands to deploy microbiome science in its formulations, Esse has witnessed the encouraging rise in awareness of probiotic skincare recently. As more people learn…